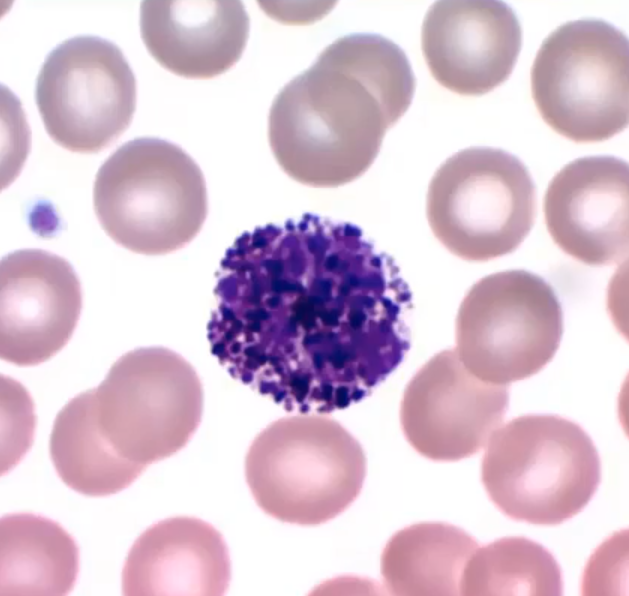

no skeleton, respiratory, epithelial
1/95
There's no tags or description
Looks like no tags are added yet.
Name | Mastery | Learn | Test | Matching | Spaced |
|---|
No study sessions yet.
96 Terms
Traits of the Liver
Detoxifies
Largest organ in non-ruminants
Deteriorates with age
Regenerative
Animals without gallbladder
Horses or rats
What do Alpha / Beta / Delta cells produce
Alpha: Glucagon (increases blood sugar)
Beta: Insulin (decreases blood sugar)
Delta: Somatostatin

What is red
Pancreas
Parenchyma and the parts its made of
Functional units of an organ
Red pulp: erythrocyte storage
White pulp: site of immune response

What is this
Spleen
Look for darkened color and poop shape

Appendix and what species it’s important
Rabbits, important in digestion
Vestigal in many species
Originally for cellulose digestion, reservoir for beneficial bacteria
Cattle calf digestive special traits
Esophageal groove bypasses rumen to let milk go straight to abomasum
milk is digested like a monogastric, still can eat grass and digest like a ruminant though
as calf grows the rumen will grow

What is this the lining of + details
Papillae in the rumen
longer the better quality feed there is = more VFA produced
Eructation
Burping to allow ruminants to expel fermentation gases
if unable, will cause bloat and cause pressure on lungs and heart
she ferment in my rumen til I eructate

What is this the lining of + details
Reticulum “honey comb stomach”
where cows get hardware disease (metal object inside, solved with swallowed magnet")
Storage for regurgitation to cud,

What is this the lining of + details
Omasum
Folds increase surface area for increased absorption
Water and nutrient absorption
“o ma sum tripe”

What is this the lining of
abomasum
similar to monogastrics, chemical digestion
Function of crop + species without crops
Soften food
control rate of food moving through GI
Owls and geese

Red
Gizzard
Mechanical stomach
muscular, stones or grit is stored here

Yellow
Proventriculus
True stomach, chemical digestion

3 + function
Ceca
Two blind pouches, bacterial fermentation for undigested food

Yellow
Yellow: Cloaca

Circle
Renal capsule
Surrounds kidney
protection and support

Label + Components
Adrenal Gland
Made of Adrenal Medulla + Adrenal Cortex
Adrenal Cortex Hormones
Epinephrine (Adrenaline)
Noepinephrine (regular homeostasis)
Adrenal Cortex Hormones
Glucocorticoids (Cortisol)
Mineralocorticoids (Aldosterone)
Importance of kidneys
Conservation of water
composition of body fluid is determined by what kidneys keep
“paired retroperitoneal organs” = separated from abdominal cavity

Green
Renal pelvis
Opening for ureter, veins and artery to enter kidney
makes the bean shape of the kidney
Renal cortex function
Formation of urine in kidneys
Erythropoietin production
Renal Corpuscle
Glomerlulus + Bowman’s Capsule
Glomerlulus: Capillaries
Bowman’s Capsule:" protective capsule of simple squamous
main point of filtration

Yellow
Red
Yellow: Renal Corpuscle
Red: Bowman’s capsule
lined in simple squamous

Green
Renal Medulla
Collect and transport urine
Multipyramidal: Cattle, Swine
Unipyramidal: Feline, Canine
Who has least/most amount of nephrons
Horses have the most nephrons per kidney
Felines have the least

What species has this kidney
Bovine

What species has this kidney
Equine

What species has this kidney
Canine

What species has this kidney
swine
Urinary Bladder function and how it is controlled
Storage of urine
Skeletal muscle “external urethral orifice” to hold in pee and prevent accidents
Urethra and gender differences
connects to bladder and expels urine
Males: travels through penis
females: empties into urogenital sinus

Red Orange Yellow
Red: Infundibulum - Catches oocyte
Orange: Ampulla - site of fertilization
Yellow: Isthmus - site of fertilization

Uterus Type + Species
Bicornuate
Mare, Cow

Uterus Type + Species
Duplex
Rabbit, Kangaroo

Uterus Type + Species
Note development
Bicornuate
Cat

Green
Renal cortex

Sow
Red; bladder
Yellow: urethra

Sow reproductive tract
Green yellow
Green: vestibule
yellow: vulva
Which avian ovary deteriorates as they age
typically the right side atrophies to reduce weight for flight
Where is avian site of fertilization?
Oviduct parts
Infindibulum
Infindibulum, Magnum, Isthmus, Shell gland, Vagina, Vent

Yellow
Vas deferens

Yellow Green
YEllow: epididymus
Green: testis
Function of cremaster muscle
temperature regulation of testis

what the fuck
Pampiniform plexus
Veins and arteries that intertwine down the testis to regulate heat

All colors
Yellow: kidney
Green: Ureters
Blue: Bladder
Red: Urethra

Top is a kidney
Circle (rabbit)
Adrenal Gland

Bull
Red
Vas deferens

Name function
Name of Ridges Depression
Cerebral cortex
Coordinate language, thought, decision
“Grey matter”
Ridges: Gyrus
Depression: Sulcus

Name
Corpus callosum

Lobe Name
Frontal Lobe

Lobe
Temporal Lobe

Name
Thalamus

Lobe
Occipital Lobe

Lobe name
Parietal lobe

Name
Hypothalamus

What + (Two halves)
Midbrain
Superior Colliculi (Function not needed to remember)
Inferior Colliculi

Name+ inside (not asking for lobe name)
Cerebellum
Has arbor vitae inside, sensory motor information

Name
Pons

What is the nerve on the red dot
Olfactory bulb

Name
Medulla Oblangata

What nerve
Optic Nerve
Optic Chiasma
Right side is processed by left cerebral hemisphere

Name
Pineal Body
What produces releasing/inhibiting hormones
hypothalamus

Name + Function of two halves
Pituitary
Posterior is storage, anterior is production

What is this
Vein lumen

What is this
Artery lumen

Where is the auricle
Aorta
2. Pulmonary Heart
3. Superior Vena Cava
4. Pulmonary Vein
5. Left auricle
6. Inferior vena cava
7. Left ventricle

Name (top left shows orientation)
Aorta
2. left auricle
3. left atriumright ventricle
interventricular septum
left ventricle

What is this
moderator band

Top
2. Bottom
Mitral valve
Chordae tendinae

Name
cornea
allows light, most sensitive part of body

Name
Ciliary body
controls shape of lens

Name
Choroid

Name
Tapetum

Name
Optic nerve

Orange name
Retina

Orange
Iris

Blue
Pupil/lens

Red
Lens

Blue
Retina

Green
vitreous humor

Gray
Iris

Green
Sclera

Blue
Pupil

Orange
Anterior compartment
Maintains pressure

Name
Band neutrophil - Immature
Segmented neutrophil - Mature
Phagocytic - ingest bacteria
Inflammation

Name
Eosinophil
Rare in blood smears (0-5%)
allergen phagocytosis, reduces inflammation from histamines
Name
Basophil
Rarest WBC
slows down blood clotting
Start inflammatory response

Name
Monocyte
largest WBC
larger molecule phagocytic
Pacman

Name
Lymphocyte
Majority nucleus
T cells and B cells